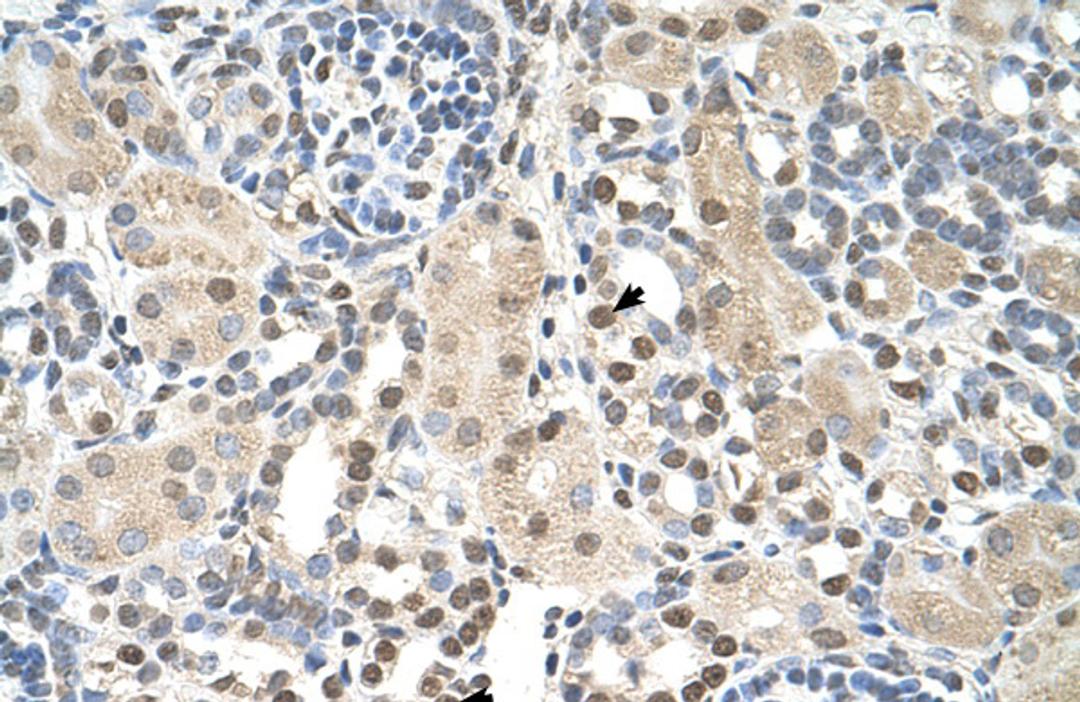
Antibody used in IHC on Human kidney.

Product & ReviewsAntibodies
PSAT1 Antibody
Product Details
- Cat. No.
- 30-187
- Type
- Primary Antibody
- Clonality
- Polyclonal
- Host
- Rabbit

The supplier does not provide quotations for this antibody through SelectScience. You can search for similar antibodies in our Antibody Directory.
Biological Information
- Clonality: Polyclonal
- Host: Rabbit
- Reactivity: Dog (Canine), Human, Mouse, Rat
- Antigen: PSAT1
- Source: Antibody is purified by peptide affinity chromatography method.
- Gene: 29968
Handling
- Quantity: 100 ul
- Storage: For short periods of storage (days) store at 4°C. For longer periods of storage, store PSAT1 antibody at -20°C. As with any antibody avoid repeat freeze-thaw cycles.
- Buffer: Purified antibody supplied in 1x PBS buffer with 0.09% (w/v) sodium azide and 2% sucrose.
Applications
- ELISA (ELISA)
- Immunohistochemistry (IHC)
- Western Blotting (WB)